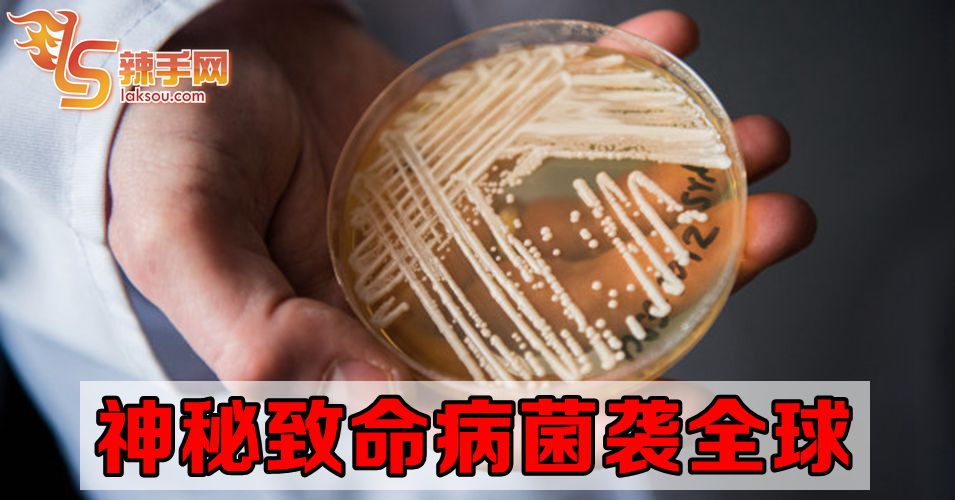
神秘病菌袭击全球

(吉隆坡7日讯)神秘致命病菌“耳念珠菌”(Candida auris)目前正在全球扩散!
根据美国《纽约时报》报导,“耳念珠菌”目前已在欧洲、亚洲、北美洲、南美洲及非洲的医疗机构造成感染,而美国纽约州、新泽西州及伊利诺州迄今已接获587宗感染耳念珠菌个案。
报导指出,这病菌是近年被发现,美国疾病控制和预防中心(CDC)已將之列入紧急威胁病菌名单。
报导说,耳念珠菌是具有多重抗药特性,攻击免疫系统衰弱的病人,它与大多数其他念珠菌属不同的是,这病菌会在医疗机构內传播,可能威胁全球公衞及医疗,引起业界相当大的关注。
报导说,耳念珠菌的徵状是平常的发烧、肌肉痛及疲倦,但感染者,特別是已带病的人,会因这些徵状而致命。